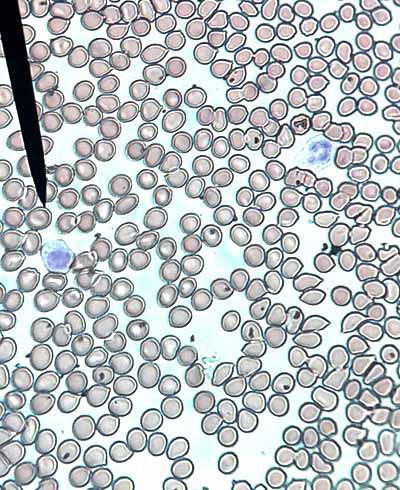

¿Qué es el sistema hematopoyético?
El sistema hematopoyético es el conjunto de órganos y tejidos en el que se forman, diferencian, reciclan y destruyen los elementos de la sangre. Es decir, abarca los sitios donde se originan, maduran y ejercen su acción funcional.
También se considera parte del sistema hematopoyético el sistema fagocítico mononuclear, el cual se encarga de eliminar las células de la sangre que ya no son funcionales, manteniendo el equilibrio. En este sentido, se puede decir que el sistema hematopoyético lo forman la sangre, los órganos y tejidos hematopoyéticos y el sistema retículo endotelial.
Por otra parte, los órganos hematopoyéticos (formación y maduración de las células sanguíneas) se clasifican en órganos primarios y secundarios. Los órganos primarios son la médula ósea y el timo, en tanto que los secundarios son los ganglios linfáticos y el bazo.
La formación de las células hematopoyéticas cumple un sistema complejo de jerarquía en el que cada tipo celular va dando origen a una progenie un poco más diferenciada, hasta llegar a las células maduras que salen al torrente sanguíneo.
La falla en el sistema hematopoyético origina enfermedades graves que comprometen la vida del paciente.
Funciones del sistema hematopoyético
El tejido hematopoyético es el lugar donde se lleva a cabo la formación y maduración de los elementos formes de la sangre. Esto incluye los hematíes y las plaquetas y las células del sistema inmunitario. Es decir, es el encargado de llevar a cabo la eritropoyesis, granulopoyesis, linfopoyesis, monocitopoyesis y megacaripoyesis.
La sangre es uno de los tejidos más dinámicos del cuerpo. Este tejido se encuentra constantemente en movimiento y sus células requieren ser renovadas constantemente. La homeostasis de este sistema sanguíneo está a cargo del tejido hematopoyético.
Cabe destacar que cada linaje celular cumple diversas funciones de gran importancia para la vida.
Eritrocitos o glóbulos rojos
Los eritrocitos son las células encargadas de llevar el oxígeno a los diversos compartimientos del cuerpo humano. Los eritrocitos miden 8 µ de diámetro, pero gracias a su gran flexibilidad pueden pasar por los capilares más pequeños.
Glóbulos blancos o leucocitos

Los glóbulos blancos, o leucocitos, son el sistema de defensa del organismo. Están en permanente vigilancia en la circulación sanguínea y aumentan en procesos infecciosos para neutralizar y eliminar al agente agresor.
Estas células secretan sustancias quimiotácticas para atraer a ciertos tipos de células a un sitio determinado, de acuerdo a la necesidad. Esta respuesta celular inespecífica está liderada por los segmentados neutrófilos y los monocitos.
También secretan citocinas capaces de activar elementos de defensa del tipo humoral inespecíficos, como el sistema de complemento, entre otros. Posteriormente, se activan los elementos de la respuesta específica, como los linfocitos T y B.
Plaquetas
Las plaquetas cumplen con el mantenimiento de los endotelios a través del proceso de la coagulación, en la que participan de forma activa. Cuando existe alguna lesión, las plaquetas son atraídas y se agregan de forma numerosa para formar un tapón e iniciar el proceso de reparación del tejido dañado.
Al finalizar la vida útil de cada célula, se eliminan por el sistema fagocítico mononuclear, distribuido por todo el organismo con células especializadas para esa función.
Tejidos del sistema hematopoyético
El tejido hematopoyético posee una estructura compleja organizada en niveles de jerarquía, simulando una pirámide, en donde participan células maduras tanto del linaje linfoide como mieloide, y también algunas células inmaduras.
Los tejidos hematopoyéticos se dividen en tejido mieloide y tejido linfoide (generación, diferenciación y maduración de células), y el sistema fagocítico mononuclear (destrucción o eliminación de células).
Tejido mieloide
Está conformado por la médula ósea. Esta se encuentra distribuida en el interior de los huesos, especialmente en la epífisis de los huesos largos y en los huesos cortos y planos. Específicamente, se ubica en los huesos de las extremidades superiores e inferiores, huesos del cráneo, del esternón, las costillas y las vértebras.
El tejido mieloide es donde se forman los distintos tipos de células que conforman la sangre. Es decir, los eritrocitos, monocitos, plaquetas y las células granulocíticas (neutrófilos, eosinófilos y basófilos).
Tejido linfoide
Se divide en tejido linfoide primario y secundario.
- El tejido linfoide primario está constituido por la médula ósea y el timo: en la médula ósea se lleva a cabo la linfopoyesis y la maduración de los linfocitos B, mientras que en el timo se maduran los linfocitos T.
- El tejido linfoide secundario lo conforman los nódulos linfoides de la médula ósea, ganglios linfáticos, bazo y tejido linfoide asociado a mucosas (apéndice, placas de Peyer, amígdalas, adenoides).
En estos lugares, los linfocitos entran en contacto con los antígenos, siendo activados para ejercer funciones específicas en el sistema inmunológico del individuo.
El sistema fagocítico monocuclear
El sistema fagocítico mononuclear, también llamado sistema retículo endotelial, ayuda en la homeostasis del sistema hematopoyético, ya que es el encargado de eliminar las células que ya no son competentes o que han cumplido su tiempo de vida útil.
Está formado por células provenientes del linaje monocítico, que incluye los macrófagos de los tejidos, los cuales cambian de nombre de acuerdo al tejido en el que se encuentren.
Por ejemplo: histiocitos (macrófagos del tejido conjuntivo), células de Kupffer (macrófagos del hígado), células de Langerhans (macrófagos de la piel), osteoclastos (macrófagos del tejido óseo), célula de microglía (macrófago del sistema nervioso central), macrófagos alveolares (pulmón), entre otros.
Histología del sistema hematopoyético
Las células del tejido hematopoyético cumplen con la siguiente regla: mientras más inmadura sea la célula, tendrán mayor capacidad para auto renovarse pero menor poder para diferenciarse. Por otra parte, mientras más madura esté una célula, más perderá la capacidad de auto renovarse pero aumentará su poder de diferenciarse.
Células madres hematopoyéticas (CMH)
Son células multipotenciales que tienen la capacidad de auto renovarse en el tiempo, por tanto, garantizan su repoblación, manteniéndose así durante toda la vida para el mantenimiento de la homeostasis de la sangre. Se encuentran en un número muy pequeño (0,01%).
Es la célula más inmadura o indiferenciada que se encuentra en la médula ósea. Se divide de forma asimétrica.
Una pequeña población se divide para formar entre 1011 a 1012 células inmaduras (progenitores hematopoyéticos multipotentes) para la renovación de las células circulantes y también para el mantenimiento de la población dentro de la médula ósea. Otro porcentaje se mantiene sin división.
Progenitores hematopoyéticos multipotentes
Estas células tienen mayor capacidad de diferenciación, pero escaso poder para auto renovarse. Es decir, han perdido algunas propiedades de su precursor (célula madre).
A partir de esta célula se formarán los progenitores mieloides o linfoides pero no ambos. Esto quiere decir que una vez que se forma responderá a factores de crecimiento para dar origen a un progenitor del linaje mieloide o a un progenitor del linaje linfoide.
Las células progenitoras del linaje mieloide son el Progenitor Megacariocítico-Eritroide (PME) y la Unidad Formadora de Colonias Granulocítica o Macrofágica (CFU-GM). La célula progenitora del linaje linfoide se denomina Progenitor Común Linfoide (PCL).
Pero estas células hematopoyéticas multipotentes que darán origen a los diferentes linajes son células morfológicamente indistinguibles entre sí.
Estas células, de acuerdo a la diferenciación, tendrán como función la formación de un linaje específico de células, pero no mantiene su propia población.
Progenitores mieloides
Estas células tienen alta capacidad de diferenciación.
El Progenitor Megacariocítico-Eritroide (PME) dará origen a las células precursoras de las plaquetas y de los eritrocitos, y la Unidad Formadora de Colonias Granulocítica o Macrofágica (CFU-GM) dará origen a las diversas células precursoras de la serie granulocíticas y de los monocitos.
Las células que provienen del Progenitor Megacariocítico-Eritroide (PME) reciben los siguientes nombres: Unidad Formadora de Colonias Megacariocíticas (UFC-Meg) y Unidad Formadora de Burst Eritroide (BFU-E).
Las que provienen de la Unidad Formadora de Colonias Granulocítica o Macrofágica (CFU-GM) se denominan: Unidad Formadora de Colonia Granulocítica (UFC-G) y Unidad Formadora de Colonia Macrofágica (UFC-M).
Progenitores linfoides
El Progenitor Común Linfoide (PCL) tiene alta capacidad para diferenciarse y producir precursores de linfocitos T, linfocitos B y linfocitos NK. Estos precursores se denominan Pro-linfocito T (Pro-T), Pro-linfocito B (Pro-B) y Pro linfocito citotóxico natural (Pro-NK).
Células maduras
Están comprendidas por las plaquetas, los eritrocitos, la serie granulocítica (los segmentados neutrófilos, segmentados eosinófilos y segmentados basólifos), monocitos, linfocitos T, linfocitos B y linfocitos citotóxicos.
Estas son las células que pasan al torrente sanguíneo, las cuales son fácilmente reconocidas de acuerdo a las características morfológicas que poseen.
Órganos hematopoyéticos
Órganos primarios
- Médula ósea. Consta de un compartimiento rojo (hematopoyético) y uno amarillo (tejido graso). El compartimiento rojo es mayor en los recién nacidos y va disminuyendo con la edad, siendo reemplazado por el tejido graso. Por lo general, en la epífisis de los huesos largos está el compartimiento hematopoyético y en la diáfisis está el compartimiento graso.
- Timo. Es un órgano ubicado en el mediastino superior anterior. Está estructuralmente conformado por dos lóbulos, en los que se distinguen dos zonas denominadas médula y corteza. La médula está ubicada hacia el centro del lóbulo y la corteza hacia la periferia. Aquí los linfocitos adquieren una serie de receptores que completan el proceso de diferenciación y maduración.
Órganos secundarios
- Ganglios linfáticos. Juegan un papel fundamental a nivel del sistema inmune, ya que son los encargados de filtrar los agentes infecciosos que ingresan al organismo. Aquí, los antígenos del agente extraño entrarán en contacto con las células del sistema inmunológico, para luego desencadenar una respuesta inmune eficaz. Los ganglios linfáticos están distribuidos estratégicamente por todo el organismo cerca de los grandes capilares linfáticos. Se distinguen cuatro zonas muy bien definidas: cápsula, para-corteza, corteza y área medular central.
- La cápsula está constituida por tejido conectivo, presenta varias entradas de vasos aferentes linfáticos y una hendidura denominada hilio. En este sitio entran y salen los vasos sanguíneos y salen los vasos linfáticos eferentes.
- La zona de la para-corteza es rica en ciertos tipos celulares, como linfocitos T, células dendríticas y macrófagos.
- La corteza contiene dos zonas principales denominadas folículos linfoides primarios y secundarios. Los primarios son ricos en células B vírgenes y de memoria, y los secundarios contienen una zona germinal compuesta por linfocitos B activados (células plasmáticas) rodeada de una zona de linfocitos inactivos.
- El área medular central contiene los cordones medulares y los senos medulares por donde circula el líquido linfático. En los cordones medulares se encuentran macrófagos, células plasmáticas y linfocitos maduros que tras pasar por la linfa se van a incorporar a la circulación sanguínea.
- Bazo. Está ubicado cerca del diafragma en el hipocondrio izquierdo. Posee varios compartimientos, entre los que se distinguen la cápsula de tejido conectivo que se internaliza a través de septos trabeculares, la pulpa roja y la pulpa blanca.
- En la pulpa roja se da la eliminación de los eritrocitos dañados o no funcionales. Los eritrocitos pasan por los sinusoides esplénicos para luego pasar a un sistema de filtro llamado cordones de Billroth. Los eritrocitos funcionales pueden atravesar estos cordones pero los viejos quedan retenidos.
- La pulpa blanca está constituida por nódulos de tejido linfoide. Estos nódulos están distribuidos por todo el bazo, rodeando a una arteriola central. Alrededor de la arteriola se encuentran linfocitos T y más externamente hay una zona rica en linfocitos B y células plasmáticas.
Microambiente del sistema hematopoyético
El microambiente está integrado por las células hematopoyéticas y por la célula madre hematopoyética, de donde provienen todas las series celulares de la sangre.
En el microambiente hematopoyético se llevan a cabo una serie de interacciones entre una diversidad de células, entre ellas están las estromales, mesenquimales, endoteliales, adipocitos, osteocitos y macrófagos.
Estas células interactúan también con la matriz extracelular. Las diversas interacciones célula a célula ayudan al mantenimiento de la hematopoyesis. En el microambiente también se secretan sustancias que regulan el crecimiento y diferenciación celular.
Enfermedades del sistema hematopoyético
Cáncer hematológico
Existen 2 tipos: las leucemias mieloides agudas o crónicas y las leucemias linfoides agudas o crónicas.
Aplasia medular
Es la incapacidad de la médula ósea de producir los distintos linajes celulares. Puede ocurrir por varias razones, entre ellas: por tratamientos con quimioterapias para tumores sólidos, exposición constante a agentes tóxicos, generalmente de tipo laboral, y la exposición a radiaciones de tipo ionizante.
Este trastorno origina una pancitopenia severa (disminución importante en el número de eritrocitos, leucocitos y plaquetas).
Enfermedades genéticas del sistema hematopoyético
Estas incluyen anemias de tipo hereditarias e inmunodeficiencias.
Las anemias pueden ser:
Anemia de Fanconi
En esta enfermedad se ven comprometidas las células madre hematopoyéticas. Es una enfermedad rara hereditaria recesiva y existe una variante ligada al cromosoma X.
La enfermedad trae consecuencias congénitas, como polidactilia, manchas marrones en piel, entre otras malformaciones. Presentan anemia manifestada desde los primeros años de vida por falla de la médula ósea.
Estos pacientes tienen una gran disposición genética a sufrir de cáncer, específicamente leucemia mieloide aguda y carcinoma escamoso.
Inmunodeficiencias combinadas graves
Son enfermedades raras, congénitas, que producen una inmunodeficiencia severa primaria. Los pacientes con esta anomalía necesitan vivir en un ambiente estéril, ya que son incapaces de interactuar con los microorganismos más inofensivos, lo cual es una tarea muy difícil. Por este motivo se les conoce como “niños burbujas”.
A una de estas enfermedades se le denomina deficiencia en la DNA-PKcs.
Deficiencia en la proteína quinasa dependiente de ADN (DNA-PKcs)
Esta enfermedad es muy rara y se caracteriza por la ausencia de células T y B. Solo está reportada en 2 casos.
Referencias
- Lañes, E. Órganos y tejidos del sistema inmune. Departamento de Microbiología. Recuperado de ugr.es.
- Hematopoyesis. Recuperado de es.wikipedia.org.
- Muñoz, J., Rangel, A., Cristancho, M. Inmunología básica. Editor: Mérida Venezuela.
- Roitt, I. Inmunología fundamentos. 9na edición. Editorial médica Panamericana. Buenos Aires, Argentina.
- Abbas, A.. Lichtman, A. y Pober, J. Inmunología celular y molecular. 6º Ed. Sanunders-Elsevier.